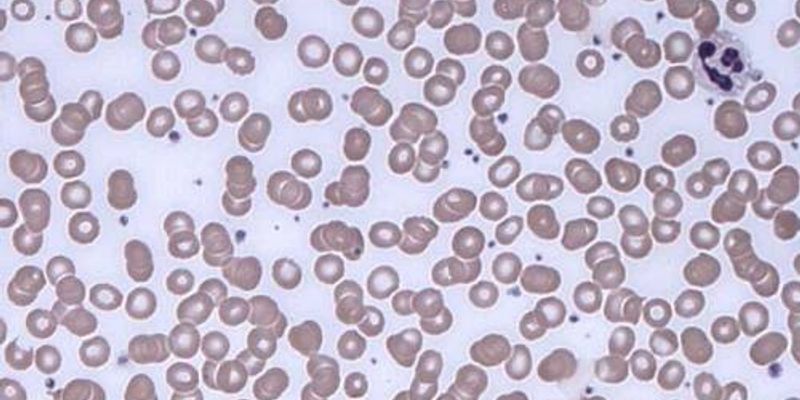

Monoclonal Gammopathy
Monoclonal Gammopathy: (MGUS) is a condition in which an unusual protein - known as monoclonal protein or M protein - is in your blood. The protein is formed in a type of white blood cell (plasma cells) in your bone marrow.
What's Popular in Monoclonal Gammopathy
-
MAY 29, 2018CancerObesity, and the factors that lead up the state of being obese, contribute to physiological function; the literature sup ...Written By: Mauri BrueggemanMAY 01, 2018CancerResearchers have developed a microfluidic device that can detect circulating plasma cells in whole blood; therefore, neg ...Written By: Mauri Brueggeman
MAY 29, 2018
Cancer
Obesity, and the factors that lead up the state of being obese, contribute to physiological function; the literature sup
...
Written By:
Mauri Brueggeman
MAY 01, 2018
Cancer
Researchers have developed a microfluidic device that can detect circulating plasma cells in whole blood; therefore, neg
...
Written By:
Mauri Brueggeman
-
JUN 27, 2023 | 10:00 AMThere is a great variability in testing for monoclonal gammopathies. During his presentation, Dr. David F. Keren, MD, Clinical Professor of Pathology at University of Michigan Health, descri...MAY 25, 2023 | 10:00 AMFree light chains, kappa (κ) lambda (λ), are produced by plasma cells and known to be an important marker in patients with Multiple Myeloma and AL Amyloidosis. The precursor con...FEB 09, 2023 | 9:00 AMDate: February 09, 2023 Time: 9:00am (PST), 12:00pm (EST), 6:00pm (CET) Monoclonal gammopathies (MGs) comprise a broad set of diseases involving the abnormal clonal proliferation of plasma c...JUN 21, 2022 | 11:00 AMDate: June 21, 2022 Time: 11:00am (PDT), 2:00pm (EDT), 8:00pm (CEST) Multiple myeloma is a cancer of the plasma cell. Plasma cells are white blood cells that make antibodies that help to pro...MAR 01, 2022 | 9:00 AMDate: March 1, 2022 Time: 9:00am (PST), 12:00pm (EST) Dr. David F Keren currently serves as a Professor of Pathology at the University of Michigan (Michigan Medicine). Dr. Keren received his...
JUN 27, 2023 | 10:00 AM
There is a great variability in testing for monoclonal gammopathies. During his presentation, Dr. David F. Keren, MD, Clinical Professor of Pathology at University of Michigan Health, descri...
MAY 25, 2023 | 10:00 AM
Free light chains, kappa (κ) lambda (λ), are produced by plasma cells and known to be an important marker in patients with Multiple Myeloma and AL Amyloidosis. The precursor con...
FEB 09, 2023 | 9:00 AM
Date: February 09, 2023 Time: 9:00am (PST), 12:00pm (EST), 6:00pm (CET) Monoclonal gammopathies (MGs) comprise a broad set of diseases involving the abnormal clonal proliferation of plasma c...
JUN 21, 2022 | 11:00 AM
Date: June 21, 2022 Time: 11:00am (PDT), 2:00pm (EDT), 8:00pm (CEST) Multiple myeloma is a cancer of the plasma cell. Plasma cells are white blood cells that make antibodies that help to pro...
MAR 01, 2022 | 9:00 AM
Date: March 1, 2022 Time: 9:00am (PST), 12:00pm (EST) Dr. David F Keren currently serves as a Professor of Pathology at the University of Michigan (Michigan Medicine). Dr. Keren received his...
FEB 23, 2021 | 8:00 AM
Date: February 23, 2021 Time: 8:00am (PST), 11:00am (EST) The analysis of serum free light chains (FLC) is now standard of care in the screening, diagnosis, and monitoring of patients suspec...
DATE: December 5, 2017TIME: 10:00AM PT, 1:00PM ET Monoclonal Gammopathies (MG) are characterized by chromosomal aberration of B-cells or plasma cells resulting in benign or mal...
Traditional testing methods for monoclonal protein in Plasma Cell Dyscrasias correctly identify a majority of patients. However, limitations in these methods can cause patients to be missed...
Speaker:
Richard O'Hara, PhD
-
MAY 28, 2014 | 6:00 AM PDTThis year will be our 5th Annual Event in the Clinical Diagnostics & Research Virtual Event Series. Attendees can earn free CME and CE Credits....
MAY 28, 2014
| 6:00 AM PDT
This year will be our 5th Annual Event in the Clinical Diagnostics & Research Virtual Event Series. Attendees can earn free CME and CE Credits....